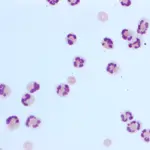
Featured Image

A 1-year-old spayed female boxer is presented for a 4-day history of lethargy, anorexia, fever, and neck pain.
History
The owners report a waxing and waning history of neck pain, fever, decreased appetite, and lethargy over the past 5 months. The dog is well supervised and has had no witnessed episodes of trauma. Short courses of antibiotics and nonsteroidal antiinflammatory medication and a 2-week tapering course of prednisone (initial dose, 2 mg/kg Q 24 H) appeared to produce improvement in the clinical signs and resolution of the fever, but signs quickly returned 48 to 72 hours after medications were discontinued.
Physical Examination
The dog is depressed but alert and responsive (Figure 1). The mucous membranes are pink and slightly tacky. Skin elasticity suggests 5% to 7% dehydration. Capillary refill time is 1.5 seconds, temperature is 103.6° F, and heart rate is 90 beats/minute with strong and synchronous pulses; no murmur or arrhythmia is auscultated. The lungs are clear and no crackles or wheezes are heard.
The dog is guarding her neck but does not show overt signs of pain. Her back is arched. A mild deficit in conscious proprioception is demonstrated in the left hindlimb; neurologic examination, including cranial nerve examination, shows no other abnormalities.
Diagnostics
Results of a complete blood count show leukocytosis (23,000/mcL) and mature neutrophilia (18,400/mcL). Findings from a serum biochemical profile and urinalysis show no abnormalities.
ASK YOURSELF...
What are the differential diagnoses for this patient’s clinical sign of neck pain?
What are possible causes of the elevated temperature?
What are possible diagnostic studies to help rule out or confirm a diagnosis?
Diagnosis: Steroid-responsive meningitis
Steroid-responsive meningitis is an aseptic inflammatory process that can result in fever, neck pain, neurologic abnormalities (eg, delayed proprioceptive responses, gait abnormalities, hypermetria), and signs of general malaise (eg, anorexia, lethargy).
It is a common cause of meningitis in young dogs, and diagnosis is based on finding aseptic suppurative CSF (Figure 2) in an adult dog younger than 2 years of age, after other causes of meningitis have been excluded. Clinical signs of neck pain and fever usually respond to therapy with corticosteroids.
Cervical Pain
Cervical (neck) pain can be a frustrating problem for both veterinarians and owners. Clinical signs of cervical disease may be mild and include reluctance to move the head or neck, lameness, and general signs of malaise (lethargy, anorexia). More severe signs may include loss of conscious proprioception/ataxia, loss of voluntary motor function, and deep pain and complete paralysis of all 4 legs.
Differential diagnoses for cervical pain include degenerative disk disease, cervical spondylomyelopathy, ischemic myelopathy, infectious or inflammatory disease, traumatic events, and neoplasia. History, signalment, physical examination findings, and diagnostic testing are important when localizing the lesion and making a diagnosis.
Caudal cervical myelopathy, ischemic myelopathy (eg, fibrocartilaginous embolism), and infectious or inflammatory disease are more likely in young, medium- to large-breed dogs. Conversely, intervertebral disk disease and neoplasia are less common in dogs with this signalment.
Fever
Veterinarians commonly treat febrile patients with antibiotics even when a specific infectious agent has not been identified. When empirical therapy is ineffective, several questions must be asked:
Is the antibiotic inappropriate for the pathogen?
Is the antibiotic effective at the target tissue site?
Was the antibiotic prescribed at an adequate dose and duration?
Are other infectious processes possible that may not be sensitive to antibiotics (eg, viral, fungal, and protozoal infections)?
Alternatively, if empirical therapy is ineffective, fever may not be a sign of infection. Drug reactions, aseptic inflammation, immune-mediated disease, neoplasia, and a variety of other processes may result in fever.
Steroid-Responsive Meningitis
Steroid-responsive meningitis should be considered as a differential for young adult, medium- to large-breed dogs that present with vague clinical signs, such as a waxing and waning fever and neck pain. Findings on physical examination and routine (noninvasive) diagnostic procedures are usually unremarkable or nonspecific, and infectious disease titers are negative.
Diagnosis is suggested by the finding of elevated numbers of neutrophils in CSF and confirmed by a clinical response to immunosuppressive doses of corticosteroids. Often, elevation of CSF nucleated cell counts is the only abnormality found.
Other diagnostic studies, such as radiography, arthrocentesis, CSF cytologic analysis, serum and CSF infectious disease titers, and MRI, may be necessary to exclude other disease processes and confirm the diagnosis. (See Box for further information on diagnostic workup.)
DID YOU ANSWER…
Intervertebral disk disease, cervical spondylomyelopathy, ischemic myelopathy, infectious or inflammatory disease, traumatic injuries, and neoplasia
Hyperthermia—Increased intrinsic heat production or increased ambient temperature, accompanied by the inability to dissipate heat. In hyperthermic animals, the hypothalamic temperature setpoint is normal. Fever—Elevation of the hypothalamic setpoint caused by inflammatory mediators. Underlying causes may be:
Infection (bacterial, viral, rickettsial, protozoal, fungal, parasitic)
Inflammation (pancreatitis, pansteatitis, panosteitis, hypertrophic osteodystrophy)
Immune-mediated disease (immune-mediated hemolytic anemia, thrombocytopenia, or polyarthritis; systemic lupus erythematosus; rheumatoid arthritis; steroid-responsive meningitis; hypereosinophilic syndrome; nodular panniculitis)
Neoplasia
Toxin ingestion (arsenic, ricin)
Drug reaction (tetracycline, trimethoprim–sulfamethoxazole, itraconazole, cimetidine).
Complete blood count and serum biochemical profile, radiographs (chest, abdomen, spine, long bones, and joints), abdominal ultrasound, urinalysis and urine culture/sensitivity, infectious disease titers (eg, rickettsial, fungal), MRI, and CSF analysis (cytology, infectious disease titers)
Treatment
Corticosteroids should be administered initially at immunosuppressive doses (prednisone, 2–4 mg/kg daily). Long-term corticosteroid therapy will be necessary in most cases. The corticosteroid therapy should be tapered to decreasing doses and alternate-day therapy over a 1- to 2-month period. Approximately 50% of cases with steroid-responsive meningitis have a recurrence of clinical signs if the steroids are discontinued or decreased too rapidly. In some cases, prednisone therapy alone will not be effective and additional medications, such as azathioprine, may be needed.
Diagnostic Plan
Neck Pain & FeverInitial diagnostics to consider when evaluating a patient with neck pain and fever include:• Complete blood cell count & serum biochemical profile• Urinalysis & urine culture/sensitivity• Chest radiographs• Infectious disease titers (eg, fungal, rickettsial), if pertinent to the history & geographic location.These are all minimally invasive, readily available, and easy to interpret. The aim is to identify obvious causes of fever.
If results of these first-line tests are unremarkable, additional investigation is warranted. Second-line tests may be more invasive, more costly, require additional equipment, and are often more difficult to interpret. Depending on the patient, possible additional tests may include:
Abdominal ultrasonography
Lymph node aspiration
Skeletal radiographs
Arthrocentesis (if joint pain or swelling is present)
Blood cultures
If a diagnosis is still unconfirmed, additional diagnostics to consider include:
CSF analysis (cytology, infectious disease titers, culture & sensitivity)
MRI